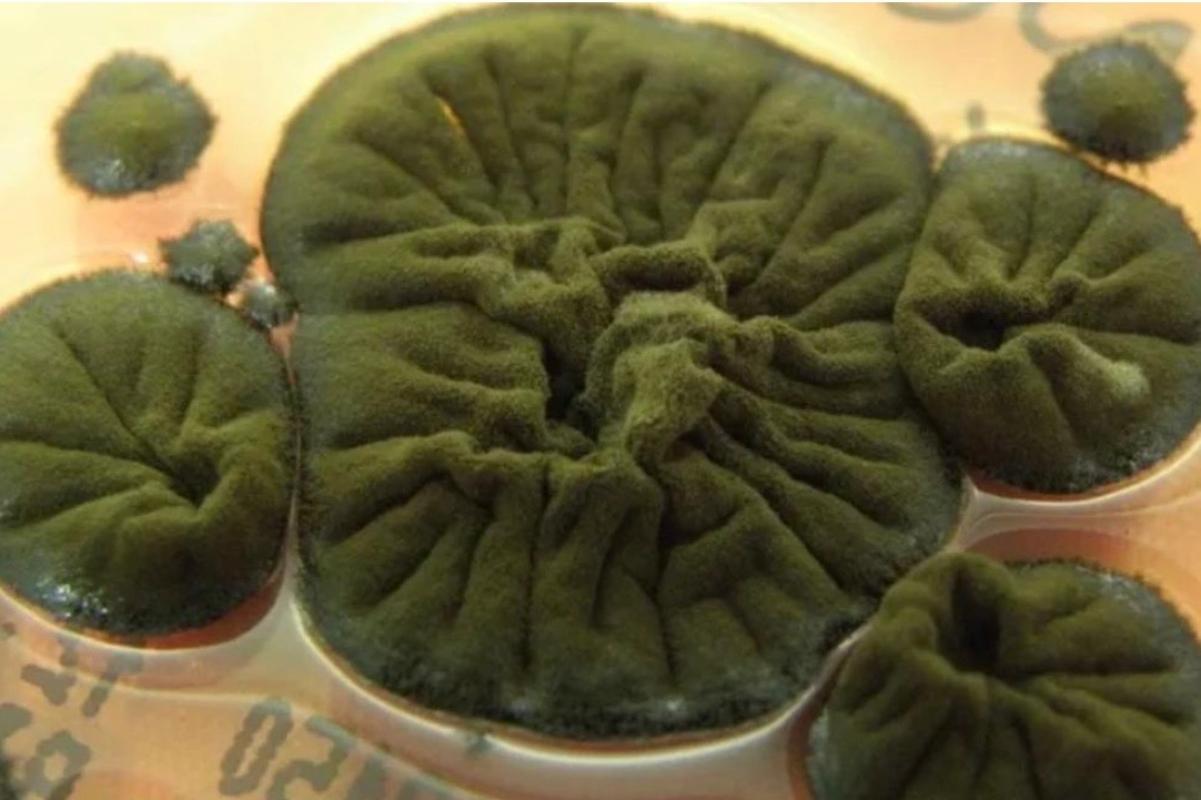
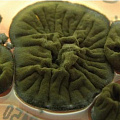

662
Чернобыльский гриб, который меняет представление о радиации и космических полётах
Учёные изучают организм, способный превращать ионизирующее излучение в энергию. Его свойства могут изменить подход NASA к защите астронавтов.

Чернобыльская зона отчуждения остаётся одной из крупнейших природных лабораторий, где эволюция идёт по своим правилам. В разрушенных конструкциях четвёртого энергоблока описаны десятки видов грибов, и почти все они окрашены в глубокий чёрный цвет — это указывает на высокое содержание меланина, который помогает выживать под мощным ионизирующим излучением.
Главным объектом исследований стал Cladosporium sphaerospermum. Он растёт на стенах реактора, где уровень радиации остаётся опасным для человека. Меланин в его клетках способен улавливать энергию ионизирующего излучения и преобразовывать её в форму, пригодную для биологических процессов. Этот механизм называют радиосинтезом: по логике он напоминает фотосинтез, только вместо света используется радиация.
Для большинства живых организмов ионизирующее излучение разрушительно: оно повреждает клетки, ломает цепочки ДНК и вызывает мутации. У Cladosporium sphaerospermum наблюдается противоположный эффект — при повышении радиационного фона гриб растёт быстрее и формирует более плотный слой.
В 2022 году образцы гриба отправили на Международную космическую станцию. Их разместили снаружи модуля, чтобы проверить поведение организма в условиях космической радиации. Датчики зафиксировали: слой гриба снижает поток излучения, а скорость его роста на орбите увеличилась примерно на 20%. Эти результаты заинтересовали NASA, поскольку традиционные материалы защиты — от свинцовых панелей до многослойных композитов — слишком тяжёлые для длительных миссий.
Сейчас обсуждается несколько сценариев применения подобных организмов. Один из них — создание «живых щитов» и биопанелей, которые можно выращивать на месте, используя минимальный набор ресурсов. Такие структуры теоретически могут стать частью лунных или марсианских баз, обеспечивая естественную защиту от радиации и самовосстановление покрытия.
Cladosporium sphaerospermum — не единственный экстремофильный организм в Чернобыльской зоне, но именно он демонстрирует потенциал для практического применения за пределами Земли. Учёные рассматривают возможность включать подобные грибы в экосистемы будущих космических поселений, где они совмещали бы функции защиты и биологической регенерации материалов.
ИЗНАНКА
Чернобыльский гриб показывает, что природа умеет адаптироваться даже к разрушительной среде. Там, где человек видит угрозу, живые системы находят источник энергии. Этот сдвиг в восприятии радиации уже влияет на инженерное мышление: самые надёжные решения для космоса могут оказаться не металлическими, а биологическими.
Фото: соцсети/ИЗНАНКА.
Читайте, ставьте лайки, следите за обновлениями в наших социальных сетях и присылайте материалы в редакцию.
ИЗНАНКА — другая сторона событий.

МВД призвало россиян меньше улыбаться для предотвращения несанкционированных платежей
Улыбка может стать причиной финансовых потерь: за год зафиксировано 43 случая ...
/ / Интересное
Автор: Денис Иванов

Прибыли российский рыбаков значительно снизились
А долги достигли триллиона рублей
/ / Интересное
Автор: Дмитрий Зорин

ВОЗ одобрила первую вакцину против оспы обезьян: новый этап в борьбе с вирусом mpox
Препарат MVA-BN, разработанный компанией Bavarian Nordic, получил официальное ...
/ / Интересное
Автор: Дарья Никитская